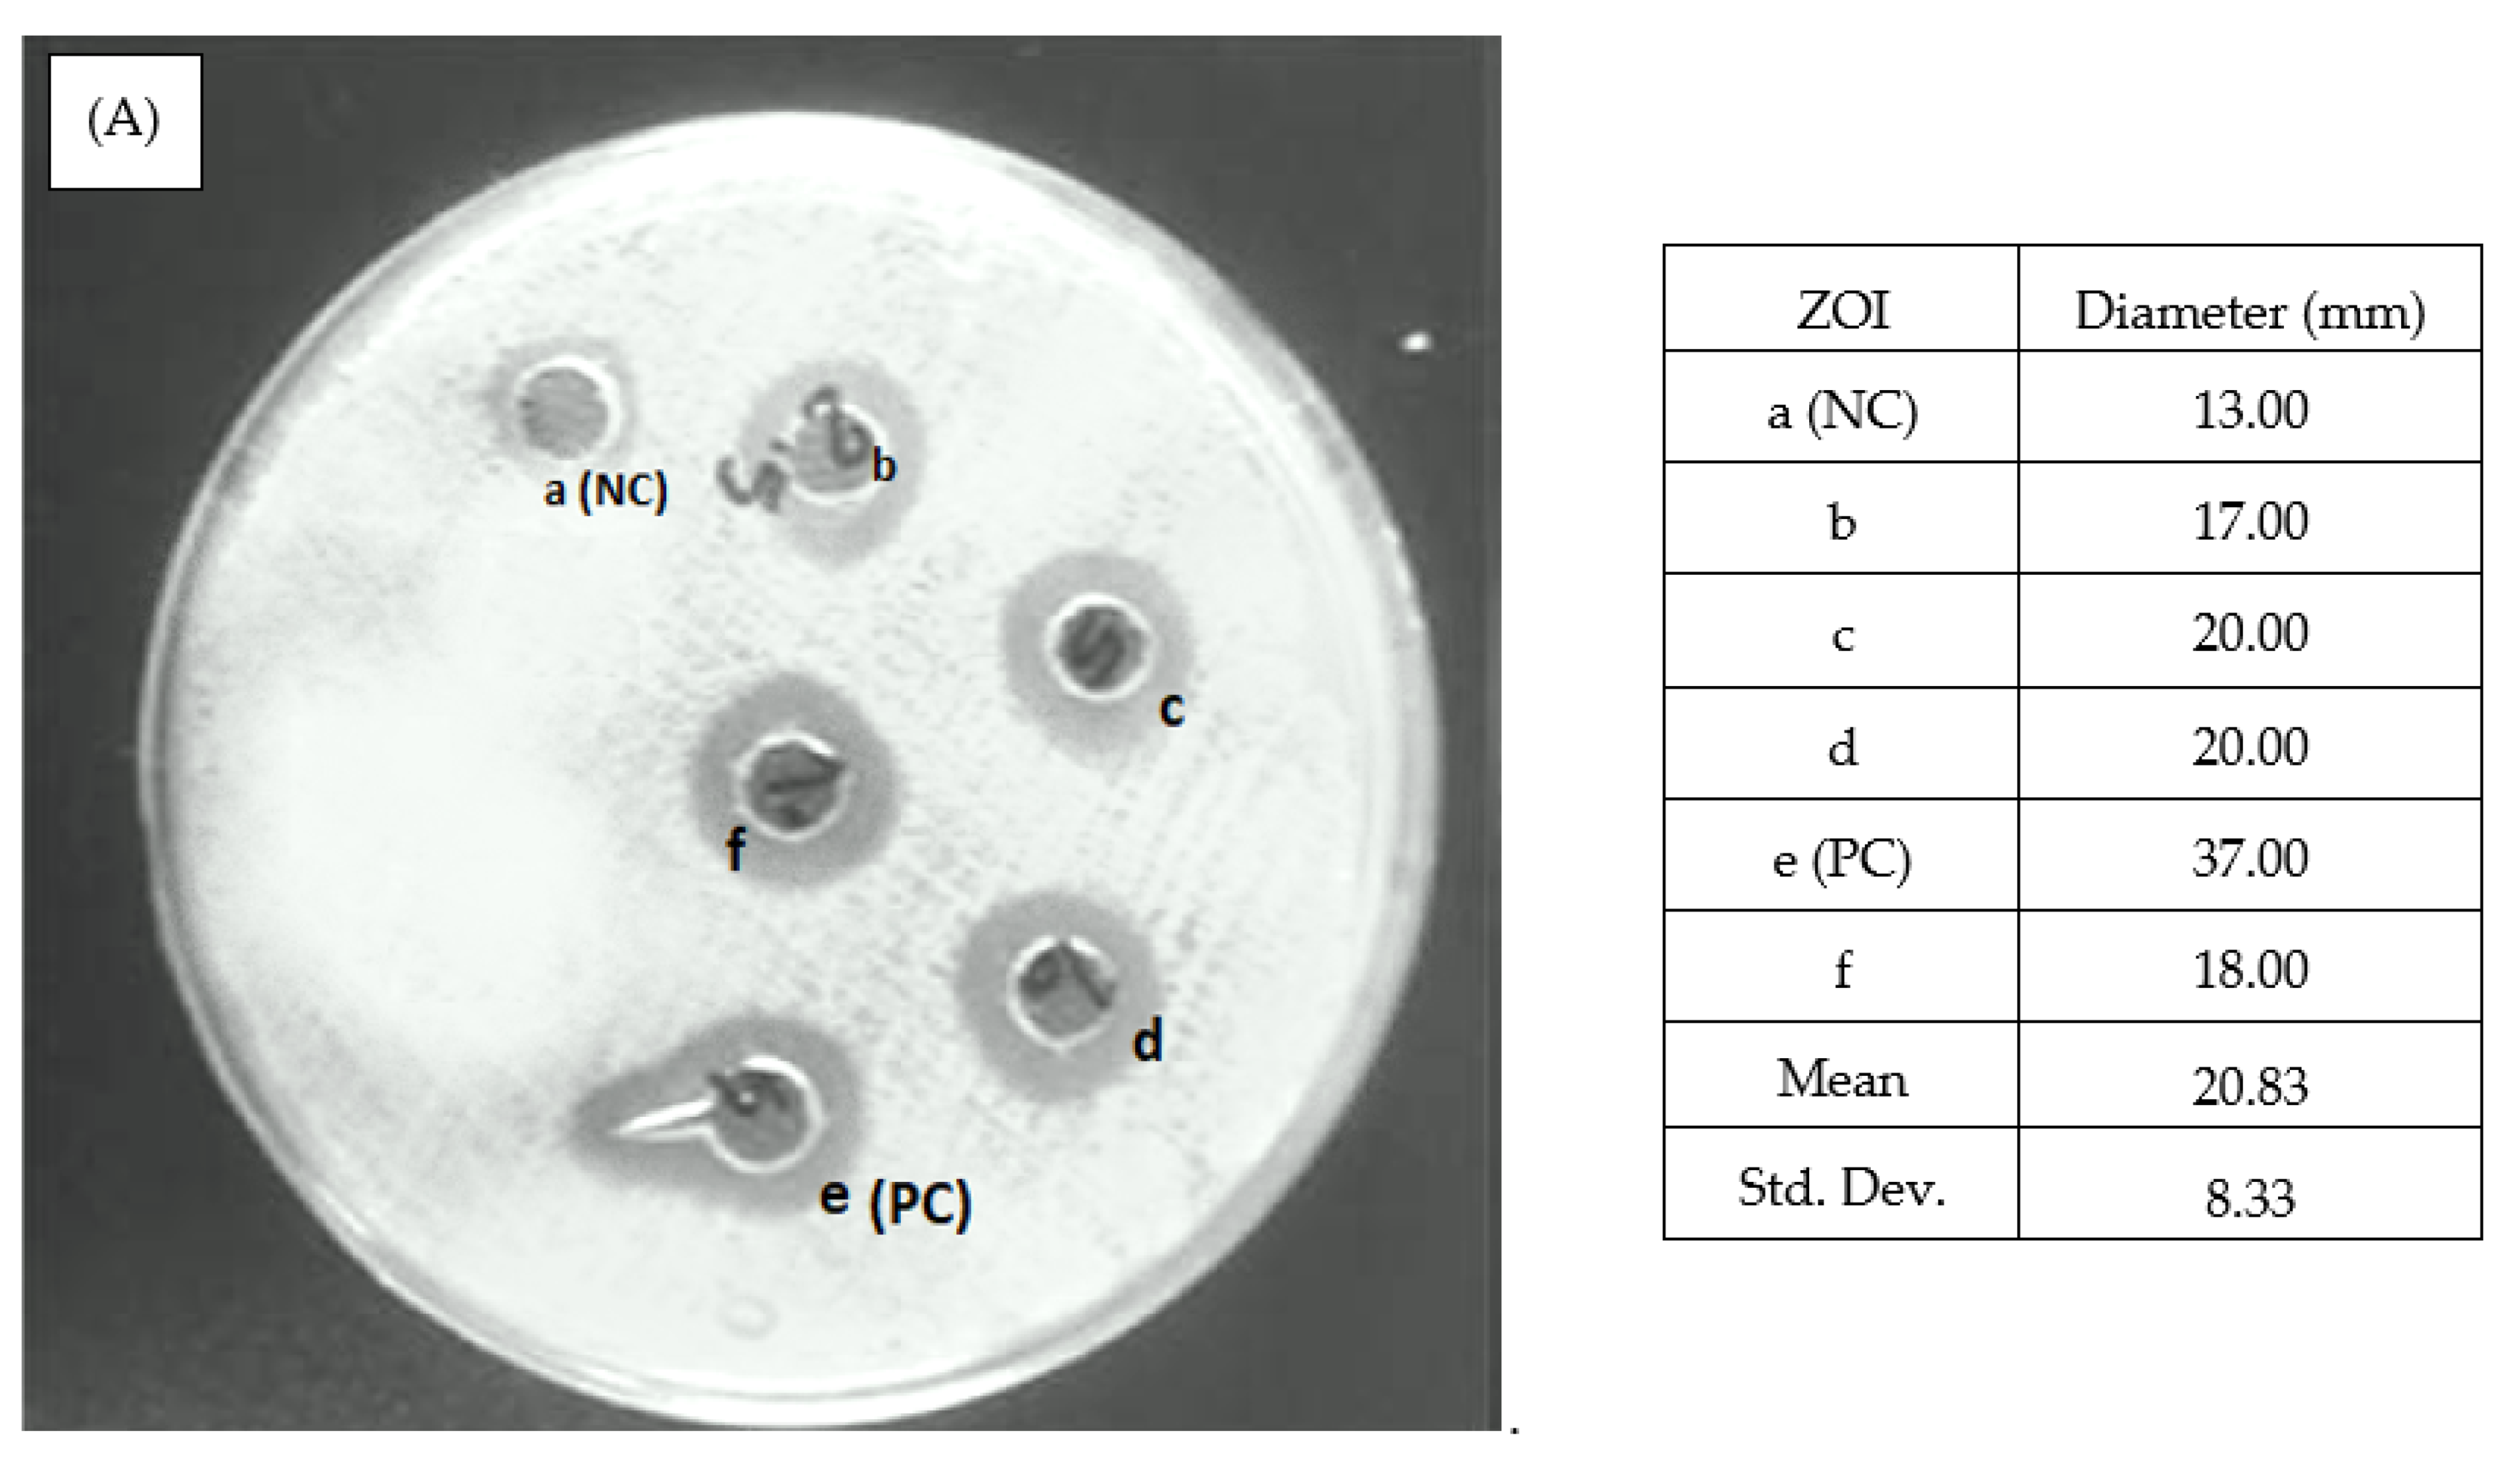
Nanomaterials 12 01725 g008a 550

Green Synthesis of Silver Nanoparticles Using Allium cepa var. Aggregatum Natural Extract: Antibacterial and Cytotoxic Properties
Abstract
:1. Introduction
| S.NO | Author/Citation | Route of Synthesis | Metal Nanoparticles | Size of the NPs | Antibacterial Activity | In Vitro Studies |
|---|---|---|---|---|---|---|
| 1 | Pradeep Kumar et al. (2020) [17] | Green Synthesis | MZ-AgNPs | 84 nm | MIC 50 µg/mL ZOI: 16.66 ± 0.57 mm 14.6 ± 0.57 mm @Staphylococcus aureus, Salmonella typhii | Red blood cells (RBC) and mammalian cells, HEK293 cells: Cytocompatibility *RBC count = 73%. *HEK293= 37% |
| 2 | Jung-Kul Lee et al. (2019) [18] | Green Synthesis | Ag-GSiO2 NPs | 20 nm | MIC 30 µg/mL @Staphylococcus aureus and Escherichia coli | - |
| 3 | Jung-Kul Lee et al. (2017) [19] | Green Synthesis | CELE-AgNPs | 20–50 nm | All microorganism similiar to the following: B. cereus, S. aureus, E. coli, S. typhimurium, E. faecalis, C. tropicalis, C. krusei, C. lusitaniae, C. guilliemondii, P. chrysogenum | L929 cell line: Concentrations of 0 μg/mL (control), 18 μg/mL (~IC50), and 25 μg/mL (~2 × IC50), Apoptotic cells did not show any adverse effects |
| 4 | M. Dhayalan et al. (2018) [20] | Green Synthesis | AgNPs | 5–35 nm | ZOI: Proteus vulgaris and Micrococcus luteus, 11–19 mm and 11–13 mm. respectively | HepG2 cell lines AgNPs showed ~20% decrease in the tumor cells at 10 μg/mL concentration |
| 5. | Current study | Green Synthesis | AgNPs | 50 nm | Escherichia coli and Staphylococcus aureus, ZOI:20–33 mm | MCF-7 cell line, ~20% diminution in the cancer cells for 20 g/mL |
2. Experimental Methods
2.1. Materials, Glassware, and Chemicals
2.2. Preparation of Aqueous Extract of Shallot
2.3. Synthesis of Silver Nanoparticles
2.4. Characterization Techniques
2.5. Antimicrobial Activity Assay
2.6. Minimum Inhibitory Concentration of Silver Nanoparticles
3. Results and Discussion
3.1. UV-Visible Spectrophotometer Analysis
3.2. Dynamic Light Scattering (DLS) Experiment and Transmission Electron Microscopy (TEM) Analysis
3.3. Morphological Analysis
3.4. X-ray Diffraction Analysis
3.5. X-ray Photoelectron Spectroscopy Analysis
3.6. Fourier Transform Infrared Spectroscopy Analysis
3.7. DPPH Asssay (2,2-diphenyl-1-picrylhydrazyl) Assay
3.8. Antibacterial Activity
3.9. Minimum Inhibitory Concentration of Silver Nanoparticles
3.10. (3-(4,5-dimethylthiazol-2-yl)-2,5-diphenyltetrazolium bromide) Tetrazolium (MTT) Assay
4. Conclusions
Author Contributions
Funding
Institutional Review Board Statement
Informed Consent Statement
Acknowledgments
Conflicts of Interest
References
- Tiwari, D.; Behari, J.; Sen, P. Application of nanoparticles in waste water treatment. World Appl. Sci. J. 2008, 3, 417–433. [Google Scholar]
- Gomez-Romero, P. Hybrid organic–inorganic materials—In search of synergic activity. Adv. Mater. 2001, 13, 163–174. [Google Scholar] [CrossRef]
- Narayanan, R.; El-Sayed, M.A. Shape-dependent catalytic activity of platinum nanoparticles in colloidal solution. Nano Lett. 2004, 4, 1343–1348. [Google Scholar] [CrossRef]
- Song, J.Y.; Kim, B.S. Rapid biological synthesis of silver nanoparticles using plant leaf extracts. Bioprocess Biosyst. Eng. 2009, 32, 79. [Google Scholar] [CrossRef] [PubMed]
- Banerjee, K.; Das, S.; Choudhury, P.; Ghosh, S.; Baral, R.; Choudhuri, S.K. A Novel Approach of Synthesizing and Evaluating the Anticancer Potential of Silver Oxide Nanoparticles in vitro. Chemotherapy 2017, 62, 279–289. [Google Scholar] [CrossRef] [PubMed]
- Naumih, M.N.; Peter, M.N. Green synthesis of nanomaterials from sustainable materials for biosensors and drug delivery. Sens. Int. 2022, 3, 100166. [Google Scholar]
- Rajasekhar, C.; Kanchi, S. Green Nanomaterials for Clean Environment. In Handbook of Ecomaterials; Springer: Cham, Switzerland, 2018; pp. 1–18. [Google Scholar]
- Bharathi, D.; Vasantharaj, S.; Bhuvaneshwari, V. Green synthesis of silver nanoparticles using Cordia dichotoma fruit extract and its enhanced antibacterial, anti-biofilm and photo catalytic activity. Mater. Res. Exp. 2018, 5, 055404. [Google Scholar] [CrossRef]
- Pelgrift, R.Y.; Friedman, A.J. Nanotechnology as a therapeutic tool to combat microbial resistance. Adv. Drug Deliv. Rev. 2013, 65, 1803–1815. [Google Scholar] [CrossRef]
- Bharathi, D.; Bhuvaneshwari, V. Evaluation of the Cytotoxic and Antioxidant Activity of Phyto-synthesized Silver Nanoparticles Using Cassia angustifolia Flowers. BioNanoScience 2018, 9, 155–163. [Google Scholar] [CrossRef]
- Bharathi, D.; Josebin, M.; Vasantharaj, S.; Bhuvaneshwari, V. Biosynthesis of silver nanoparticles using stem bark extracts of Diospyros montana and their antioxidant and antibacterial activities. J. Nanostruct. Chem. 2018, 8, 83–92. [Google Scholar] [CrossRef] [Green Version]
- Abdou, I.A.; Abou-Zeid, A.A.; El-Sherbeeny, M.R.; Abou-El-Gheat, Z.H. Antimicrobial activities of Allium sativum, Allium cepa, Raphanus sativus, Capsicum frutescens, Eruca sativa, Allium kurrat on bacteria. Qual. Plant. Mater. Veg. 1972, 22, 29–35. [Google Scholar] [CrossRef]
- Mnayer, D.; Fabiano-Tixier, A.-S.; Petitcolas, E.; Hamieh, T.; Nehme, N.; Ferrant, C.; Fernandez, X.; Chemat, F. Chemical Composition, Antibacterial and Antioxidant Activities of Six Essentials Oils from the Alliaceae Family. Molecules 2014, 19, 20034–20053. [Google Scholar] [CrossRef] [Green Version]
- Sittisart, P.; Yossan, S.; Prasertsan, P. Antifungal property of chili, shallot and garlic extracts against pathogenic fungi, Phomopsis spp., isolated from infected leaves of para rubber (Hevea brasiliensis Muell. Arg.). Agric. Nat. Resour. 2017, 51, 485–491. [Google Scholar] [CrossRef]
- Guzmán, K.; Kumar, B.; Vallejo, M.J.; Grijalva, M.; Debut, A.; Cumbal, L. Ultrasound-assisted synthesis and antibacterial activity of gallic acid-chitosan modified silver nanoparticles. Prog. Org. Coatings 2019, 129, 229–235. [Google Scholar] [CrossRef]
- Wang, L.; Hu, C.; Shao, L. The antimicrobial activity of nanoparticles: Present situation and prospects for the future. Int. J. Nanomed. 2017, 12, 1227–1249. [Google Scholar] [CrossRef] [PubMed] [Green Version]
- Bhawna, S.; Indu, S.; Somvir, B.; Seema, G.; Hemant, G.; Pradeep, K. Biogenic Silver Nanoparticles: Evaluation of Their Biological and Catalytic Potential. Indian J. Microbiol. 2020, 60, 468–474. [Google Scholar]
- Sachin, V.O.; Vipin, C.K.; In-Won, K.; Jung-Kul, L. Antimicrobial Activity of Biosynthesized Silver Nanoparticles Decorated Silica Nanoparticles. Indian J. Microbiol. 2019, 59, 379–382. [Google Scholar]
- Sachin, V.O.; Pawar, S.H.; Sanjay, K.S.P.; Raushan, K.S.; Sang-Yong, K.J.H.L.; Liaoyuan, Z.; Jung-Kul, L.J. Canna edulis Leaf Extract-Mediated Preparation of Stabilized Silver Nanoparticles: Characterization, Antimicrobial Activity, and Toxicity Studies. Microbiol. Biotechnol. 2017, 27, 731–738. [Google Scholar]
- Manikandan, D.; Malathi, S.; Karthick Kumar, B.; Mohammed Riyaz, S.U.; Mika, S. Eco friendly synthesis and characterization of zinc oxide nanoparticles from Aegle marmelos and its cytotoxicity effects on MCF-7 cell lines. Nanofabrication 2021, 6, 44–51. [Google Scholar]
- Azwanida, N.N. A review on the extraction methods use in medicinal plants, principle, strength and limitation. Med. Aromat. Plants 2015, 4, 3–8. [Google Scholar]
- Haytham, M.M. Green synthesis and characterization of silver nanoparticles using banana peel extract and their antimicrobial activity against representative microorganisms. J. Radiat. Res. Appl. Sci. 2015, 8, 265–275. [Google Scholar]
- Matteo, T.; Erica, L.; Marco, R.; Ilaria, M.; Simona, R.; Irene, C.; Mauro, C.F.; Lorena, P.; Michela, M. A Combined Approach Employing Chlorotoxin-Nanovectors and Low Dose Radiation to Reach Infiltrating Tumor Niches in Glioblastoma. ACS Nano 2016, 10, 2509–2520. [Google Scholar]
- Shankar, S.S.; Rai, A.; Ahmad, A.; Sastry, M. Rapid synthesis of Au, Ag, and bimetallic Au core–Ag shell nanoparticles using Neem (Azadirachta indica) leaf broth. J. Colloid Interface Sci. 2004, 275, 496–502. [Google Scholar] [CrossRef]
- Guha, G.; Rajkumar, V.; Ashok Kumar, R.; Mathew, L. Aqueous extract of Phyllanthus amarus inhibits chromium (VI)—Induced toxicity in MDA-MB-435S cells. Food Chem. Toxicol. 2010, 48, 396–401. [Google Scholar] [CrossRef] [PubMed]
- Manikandan, D.; Michael, I.J.D.; Manikandan, A.; Gandhi, N.N.; Kathiravan, K.; Baykal, A. Biogenic synthesis, characterization of gold and silver nanoparticles from Coleus forskohlii and their clinical importance. J. Photochem. Photobiol. B Biol. 2018, 183, 251–257. [Google Scholar]
- Ramteke, C.; Chakrabarti, T.; Sarangi, B.K.; Pandey, R.A. Synthesis of silver nanoparticles from the aqueous extract of leaves of Ocimum sanctum for enhanced antibacterial activity. J. Chem. 2013, 2013, 278925. [Google Scholar] [CrossRef] [Green Version]
- Jaman, M.; Chowdhury, A.; Rana, A.; Masum, S.; Ferdous, T.; Rashid, M.; Karim, M. In vitro evaluation of Ciprofloxacin Hydrochloride. Bangladesh J. Sci. Ind. Res. 2015, 50, 251–256. [Google Scholar] [CrossRef] [Green Version]
- Vikram, P.; Stéphanie, D.; Sathesh, K.; Sivasankaran, S.K.; Bhargava, A.; Jitendra, P.; Shabarinath, S.; Séamus, F. Silver Nanoparticles Induce a Triclosan-Like Antibacterial Action Mechanism in Multi-Drug Resistant Klebsiella pneumonia. Front. Microbiol. 2021, 12, 638640. [Google Scholar]
- Courtney, K.D.; Moore, J.A. Teratology studies with 2,4,5-trichlorophenoxyacetic acid and2,3,7,8-tetrachlorodibenzo-P-dioxin. Toxicol. Appl. Pharmacol. 1971, 20, 396–403. [Google Scholar] [CrossRef]
- Swadhin, K.S.; Pranesh, C.; Prasanta, S.; Santi, P.; Sinha, B. Ultrasound assisted green synthesis of poly(vinyl alcohol) capped silver nanoparticles for the study of its antifilarial efficacy. Appl. Surf. Sci. 2014, 288, 625–632. [Google Scholar]
- Manjamadha, V.P.; Muthukumar, K. Ultrasound assisted green synthesis of silver nanoparticles using weed plant. Bioprocess Biosyst. Eng. 2016, 39, 401–411. [Google Scholar] [CrossRef] [PubMed]
- Khalil, M.M.; Ismail, E.H.; El-Baghdady, K.; Zmohamed, D. Green synthesis of silver nanoparticles using olive leaf extract and its antibacterial activity. Arab. J. Chem. 2014, 7, 1131–1139. [Google Scholar] [CrossRef] [Green Version]
- Ahmad, N.; Sharma, S.; Alam, K.; Singh, V.; Shamsi, S.; Mehta, B.; Fatma, A. Rapid synthesis of silver nanoparticles using dried medicinal plant of basil. Colloids Surf. B Biointerfaces 2010, 81, 81–86. [Google Scholar] [CrossRef] [PubMed]
- Vidhu, V.; Aromal, S.; Aphilip, D. Green synthesis of silver nanoparticles using macrotyloma uniflorum. J. Spectrochim. Acta Part A Mol. Biomol. Spectrosc. 2011, 83, 392–397. [Google Scholar] [CrossRef]
- Mohammad, M.T.; Mohammed, R.A.K.; Noor, K.A.S.; Tolou, S.; Mahtab, A.; Mostafa, R.S. Green synthesis of silver nanoneedles using shallot and apricot tree gum. Trans. Nonferrous Metals Soc. China 2015, 25, 3286–3290. [Google Scholar]
- Dante, R.C.; Chamorro-Posada, P.; Vázquez-Cabo, J.; Rubinos-Lopez, O.; Sanchez-Arevalo, F.M.; Huerta, L.; Martin-Ramos, P.; Lartundo-Rojas, L.; Avila-Vega, C.F.; Rivera-Tapia, E.D.; et al. Nitrogen-carbon graphite-like semiconductor synthesized from uric acid. Carbon 2017, 121, 368–379. [Google Scholar] [CrossRef] [Green Version]
- Liu, Q.; Li, J.; Zhou, Z.; Xie, J.; Lee, J.Y. Hydrophilic Mineral Coating of Membrane Substrate for Reducing Internal Concentration Polarization (ICP) in Forward Osmosis. Sci. Rep. 2016, 6, 19593. [Google Scholar] [CrossRef] [Green Version]
- Lu, X.; Wang, J.; Al-Qadiri, H.M.; Ross, C.F.; Powers, J.R.; Tang, J.; Rasco, B.A. Determination of total phenolic content and antioxidant capacity of onion (Allium cepa) and shallot (Allium oschaninii) using infrared spectroscopy. Food Chem. 2011, 129, 637–644. [Google Scholar] [CrossRef]
- Nguyen, T.T.T.; Le, H.H.; Truong, T.V.; Doan, T.P.T.; Nguyen, T.T.T.; Nguyen, T.M.L. Application of the Response Surface Methodology for Green synthesis of silver nanoparticles using a plant extract of shallot. Egypt. J. Chem. 2020, 63, 4579–4588. [Google Scholar] [CrossRef]
- Cid, A.; Mejuto, J.; Orellana, P.; López-Fernández, O.; Rial-Otero, R.; Simal-Gandara, J. Effects of ascorbic acid on the microstructure and properties of SDS micellar aggregates for potential food applications. Food Res. Int. 2013, 50, 143–148. [Google Scholar] [CrossRef]
- Lawrence, A.A.; Prakash, J.T.J. Biogenic Synthesis of Silver Nanoparticles Using Manilkara Hexandra (Roxb.) Dubard Stem Bark Extract and It’s Physical, Chemical Characterization and Pharmaceutical Evaluation. Int. J. Appl. Pharm. 2019, 11, 79–88. [Google Scholar] [CrossRef]
- Kaviya, S.; Santhanalakshmi, J.; Viswanathan, B.; Muthumary, J.; Srinivasan, K. Biosynthesis of silver nanoparticles using citrus sinensis peel extract and its antibacterial activity. Spectrochim. Acta Part A Mol. Biomol. Spectrosc. 2011, 79, 594–598. [Google Scholar] [CrossRef] [PubMed]
- Jain, S.; Mehata, M.S. Medicinal Plant Leaf Extract and Pure Flavonoid Mediated Green Synthesis of Silver Nanoparticles and their Enhanced Antibacterial Property. Sci. Rep. 2017, 7, 15867. [Google Scholar] [CrossRef] [PubMed]
- Rai, M.; Yadav, A.; Gade, A. Silver nanoparticles as a new generation of antimicrobials. Biotechnol. Adv. 2009, 27, 76–83. [Google Scholar] [CrossRef] [PubMed]
- Priya, B.; Mantosh, S.; Aniruddha, M.; Papita, D. Leaf extract mediated green synthesis of silver nanoparticles from widely available Indian plants: Synthesis, characterization, antimicrobial property and toxicity analysis. Bioresour. Bioprocess. 2014, 1, 3. [Google Scholar]
- Sreekanth, T.V.M.; Nagajyothi, P.C.; Muthuraman, P.; Enkhtaivan, G.; Vattikuti, S.V.P.; Tettey, C.O.; Doo, H.K.; Jaesool, S.; Kisoo, Y. Ultra-sonication-assisted silver nanoparticles using Panax ginseng root extract and their anti-cancer and antiviral activities. J. Photochem. Photobiol. B Biol. 2018, 188, 6–11. [Google Scholar] [CrossRef]
- Ali, E.M.; Abdallah, B.M. Effective Inhibition of Candidiasis Using an Eco-Friendly Leaf Extract of Calotropis-gigantean mediated silver nanoparticles. Nanomaterials 2020, 10, 422. [Google Scholar] [CrossRef] [Green Version]
- Abdallah, B.M.; Ali, E.M. Green Synthesis of Silver Nanoparticles Using the Lotus lalambensis Aqueous Leaf Extract and Their Anti-Candidal Activity against Oral Candidiasis. ACS Omega 2021, 6, 8151–8162. [Google Scholar] [CrossRef]
- Angel, A.E.; Judith, V.J.; Kaviyarasu, K.; John, K.L.; Jothiramalingam, R.; Hamad, A.A.L. Green synthesis of NiO nanoparticles using Aeglemarmelos leaf extract for the evaluation of in-vitro cytotoxicity, antibacterial and photocatalytic Eco friendly synthesis and characterization of zinc oxide nanoparticles and its cytotoxicity effects|51 properties. J. Photochem. Photobiol. B 2018, 180, 39–50. [Google Scholar]
- Horie, M.; Nishio, K.; Fujita, K.; Endoh, S.; Miyauchi, A.; Saito, Y.; Iwahashi, H.; Yamamoto, K.; Murayama, H.; Nakano, H.; et al. Protein Adsorption of Ultrafine Metal Oxide and Its Influence on Cytotoxicity toward Cultured Cells. Chem. Res. Toxicol. 2009, 22, 543–553. [Google Scholar] [CrossRef]
- Hemlata, P.R.M.; Arvind, P.S.; Kiran, K.T. Biosynthesis of Silver Nanoparticles Using Cucumis prophetarum Aqueous Leaf Extract and Their Antibacterial and Antiproliferative Activity Against Cancer Cell Lines. ACS Omega 2020, 5, 5520–5528. [Google Scholar] [CrossRef] [PubMed] [Green Version]
- Bilal, M.; Rasheed, T.; Iqbal, H.M.; Li, C.; Hu, H.; Zhang, X. Development of silver nanoparticles loaded chitosan-alginate constructs with biomedical potentialities. Int. J. Biol. Macromol. 2017, 105, 393–400. [Google Scholar] [CrossRef] [PubMed]

Publisher’s Note: MDPI stays neutral with regard to jurisdictional claims in published maps and institutional affiliations. |
© 2022 by the authors. Licensee MDPI, Basel, Switzerland. This article is an open access article distributed under the terms and conditions of the Creative Commons Attribution (CC BY) license (https://creativecommons.org/licenses/by/4.0/).
Share and Cite
Shanmugam, J.; Dhayalan, M.; Savaas Umar, M.R.; Gopal, M.; Ali Khan, M.; Simal-Gandara, J.; Cid-Samamed, A. Green Synthesis of Silver Nanoparticles Using Allium cepa var. Aggregatum Natural Extract: Antibacterial and Cytotoxic Properties. Nanomaterials 2022, 12, 1725. https://doi.org/10.3390/nano12101725
Shanmugam J, Dhayalan M, Savaas Umar MR, Gopal M, Ali Khan M, Simal-Gandara J, Cid-Samamed A. Green Synthesis of Silver Nanoparticles Using Allium cepa var. Aggregatum Natural Extract: Antibacterial and Cytotoxic Properties. Nanomaterials. 2022; 12(10):1725. https://doi.org/10.3390/nano12101725
Chicago/Turabian StyleShanmugam, Jayashree, Manikandan Dhayalan, Mohammed Riyaz Savaas Umar, Mayakkannan Gopal, Moonis Ali Khan, Jesus Simal-Gandara, and Antonio Cid-Samamed. 2022. "Green Synthesis of Silver Nanoparticles Using Allium cepa var. Aggregatum Natural Extract: Antibacterial and Cytotoxic Properties" Nanomaterials 12, no. 10: 1725. https://doi.org/10.3390/nano12101725
APA StyleShanmugam, J., Dhayalan, M., Savaas Umar, M. R., Gopal, M., Ali Khan, M., Simal-Gandara, J., & Cid-Samamed, A. (2022). Green Synthesis of Silver Nanoparticles Using Allium cepa var. Aggregatum Natural Extract: Antibacterial and Cytotoxic Properties. Nanomaterials, 12(10), 1725. https://doi.org/10.3390/nano12101725

